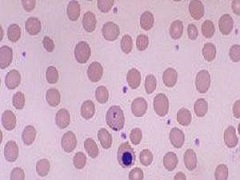

芦可替尼在全球多个国家已上市,海外药品上市情况,海外原研药/仿制药价格等,欢迎咨询海得康。
免责声明
由本文所表达的任何关于疾病的建议都不应该被视为医生的建议或替代品,请咨询您的治疗医生了解更多细节。本站信息仅供参考,海得康不承担任何责任。
版权声明:本文为原创文章,版权归海德康海外医疗所有,转载请注明出处,感谢!
原创声明:如有侵权,请联系我们删除。
北京市经济技术开发区留学生创业园
科创十四街99号33幢D座7层703室
咨询热线:400-001-9763
Copyright @ 2017 北京海得康管理咨询有限公司 All Rights Reserved
互联网药品信息服务资格证(京)-非经营性-2016-0106
免责声明:本网站展示的医药信息仅供参考,具体疾病治疗和用药细节请务必咨询医生和药师,海得康不承担任何责任
京ICP备15058342号-15 工商执照注册号/统一社会信用代码 110105019927126